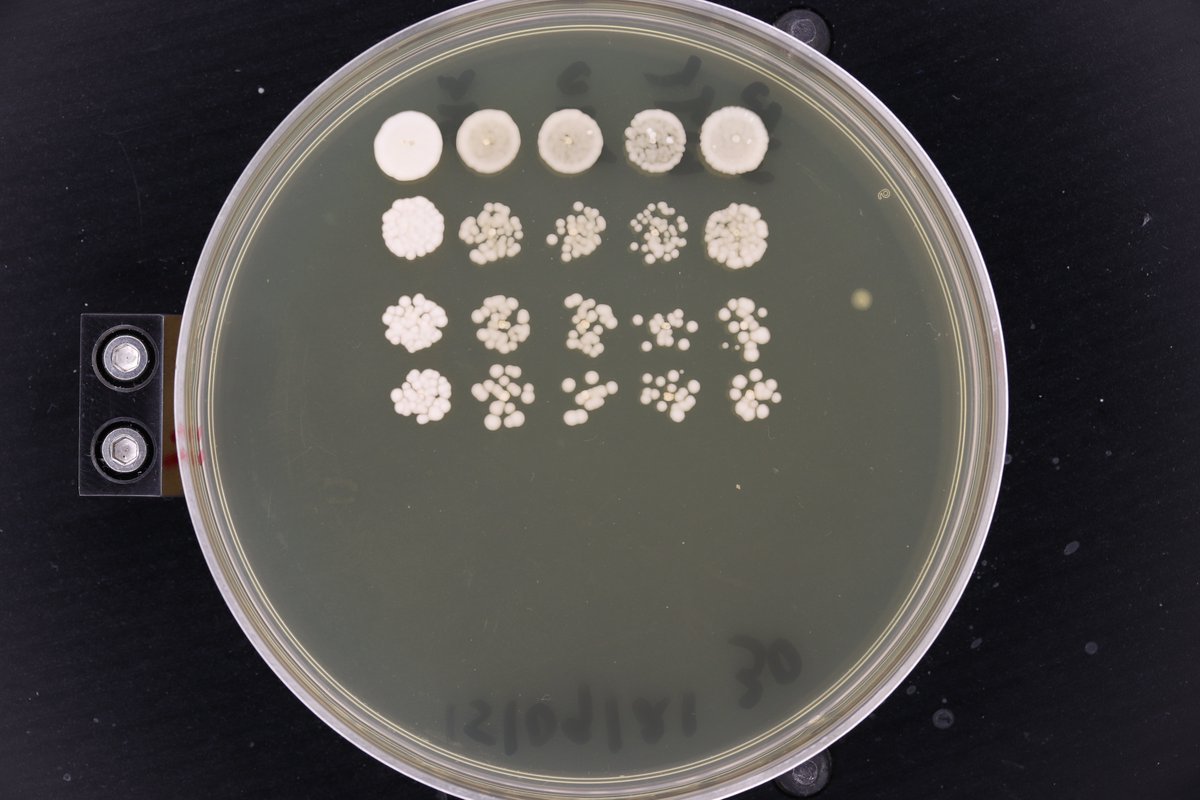
Mudabir tweet media

David Lydall retweetledi

I am setting up my lab at @cardiffuni, funded by a @wellcometrust CDA fellowship, to investigate R-loops and genome stability in the pathogenesis of neurodevelopmental disorders. I am looking for two postdocs with a passion for genome stability research to join my lab. Please RT!
English